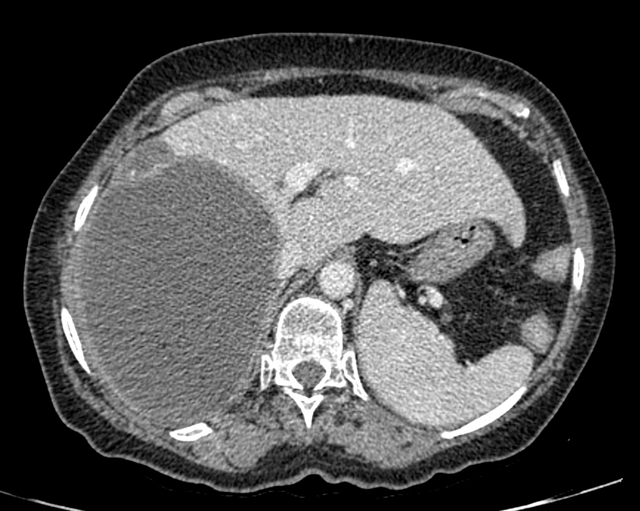

Hydatid Cyst: Image 2
Danielle Langan, DO, Josh Greenstein, MD, & Barry Hahn, MD
Full description
CT of the abdomen/pelvis shows a circumscribed multilocular cystic lesion containing multiple smaller cysts in the right hepatic lobe associated with bulging of the capsule.
Download image “Hydatid Cyst: Image 2”
- typeImage
- created on
- file formatjpg
- file size3 MB